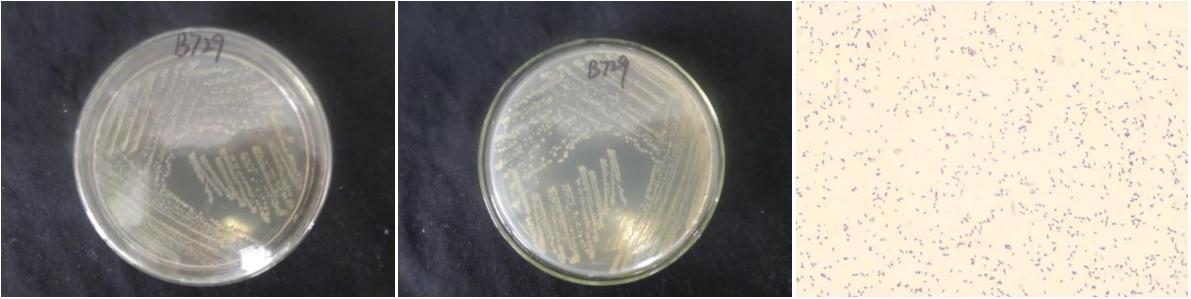

Loading...
| StrainNO | B729 |
| Classification | Bacillus |
| 16s rDNA sequence | AGTGCGGCGTGCCTATACATGCAAGTCGAGCGAATGGATTAAGAGCTTGCTCTTATGAAGTTAGCGGCGGACGGGTGAGTAACA CGTGGGTAACCTGCCCATAAGACTGGGATAACTCCGGGAAACCGGGGCTAATACCGGATAACATTTTGAACCGCATGGTTCGAA ATTGAAAGGCGGCTTCGGCTGTCACTTATGGATGGACCCGCGTCGCATTAGCTAGTTGGTGAGGTAACGGCTCACCAAGGCAAC GATGCGTAGCCGACCTGAGAGGGTGATCGGCCACACTGGGACTGAGACACGGCCCAGACTCCTACGGGAGGCAGCAGTAGGGAA TCTTCCGCAATGGACGAAAGTCTGACGGAGCAACGCCGCGTGAGTGATGAAGGCTTTCGGGTCGTAAAACTCTGTTGTTAGGGA AGAACAAGTGCTAGTTGAATAAGCTGGCACCTTGACGGTACCTAACCAGAAAGCCACGGCTAACTACGTGCCAGCAGCCGCGGT AATACGTAGGTGGCAAGCGTTATCCGGAATTATTGGGCGTAAAGCGCGCGCAGGTGGTTTCTTAAGTCTGATGTGAAAGCCCAC GGCTCAACCGTGGAGGGTCATTGGAAACTGGGAGACTTGAGTGCAGAAGAGGAAAGTGGAATTCCATGTGTAGCGGTGAAATGC GTAGAGATATGGAGGAACACCAGTGGCGAAGGCGACTTTCTGGTCTGTAACTGACACTGAGGCGCGAAAGCGTGGGGAGCAAAC AGGATTAGATACCCTGGTAGTCCACGCCGTAAACGATGAGTGCTAAGTGTTAGAGGGTTTCCGCCCTTTAGTGCTGAAGTTAAC GCATTAAGCACTCCGCCTGGGGAGTACGGCCGCAAGGCTGAAACTCAAAGGAATTGACGGGGGCCCGCACAAGCGGTGGAGCAT GTGGTTTAATTTGAAGCAACGCGAAGAACCTTACCAGGTCTTGACATCCTTTGACAACCCTAGAGATAGGGCTTTTCCTTCGGG AGCAGAGTGACAGGTGGTGCATGGTTGTTGTCAGCTCGTGTCGTGAGATGTTGGGTTAAGTCCCGCAACGAGCGCAACCCTTGA TTTTAGTTGCCATCATTTAGTTGGGCACTTTAAGGTGACTGCCGGTGACAAACCGGAGGAAGGTGGGGATGACGTCAAATCATCATGCCCCTTATGACCTGGGCTACACACGTGCTACAATGGACGGTACAAAGAGCTGCAAGACCGCGAGGTGGAGCTAATTTCATA AAACCGTTTTCAGTTCGGATTGTAGGCTGCAACTTGCCTACATGAAGCTGGAATCGCTAGTAATCGCGGATCAGCATGCCGCGG TGAATACGTTCCCGGGCCTTGTACACCCCGCCCGTCCCCCCCCGAGAGTTTGTAACCCCCGAAGTCGGTGGGGTAACCTTTTGG AGCCAGCCGCCTAAGTGACAAAG |
| Strain Morphology Photos | |
| Morphological Description | The morphology of Colony round;clam white;edge neatly;steamed bun shaped;concentric ring;slippy;sticky;waxy;The morphology of strain:Rod;having spore;spore mesophytic |